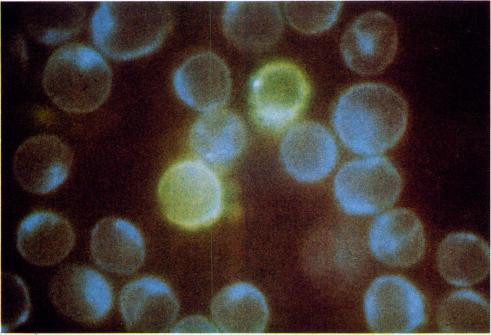
https://cdn.ncbi.nlm.nih.gov/pmc/blobs/2ba6/1541113/cbdd6e493758/clinexpimmunol00231-0115-a.jpg

用疏水荧光探针1-苯胺基-8-萘磺酸盐对胸腺细胞亚群进行表征
Characterization of cell subpopulations of the thymus by a hydrophobic fluorescent probe: 1-anilino-8-naphthalene sulphonate.
作者信息
Vaillier J, Vaillier D
出版信息
Clin Exp Immunol. 1977 Nov;30(2):283-8.
1-anilino-8-naphthalene sulphonate (ANS) is a hydrophobic fluorescent probe. ANS is not fluorescent in water or in RPMI 1640 medium, but it becomes fluorescent when bound to hydrophobic components of cells. The binding of ANS to mouse thymocytes shows that two cell subpopulations are identified, which differ in their emission wave-lengths, as reflected by their distinct 'blue' and 'green' fluorescence. This difference correlates with the DNA content of cells and this technique may characterize thymic cells in the G1 or in the S-G2 phases of the cell cycle in a quick and simple way.
1-苯胺基-8-萘磺酸盐(ANS)是一种疏水性荧光探针。ANS在水中或RPMI 1640培养基中不发荧光,但当与细胞的疏水性成分结合时会发荧光。ANS与小鼠胸腺细胞的结合表明可识别出两个细胞亚群,它们的发射波长不同,这通过其独特的“蓝色”和“绿色”荧光得以体现。这种差异与细胞的DNA含量相关,并且该技术可以快速简便地表征处于细胞周期G1期或S-G2期的胸腺细胞。